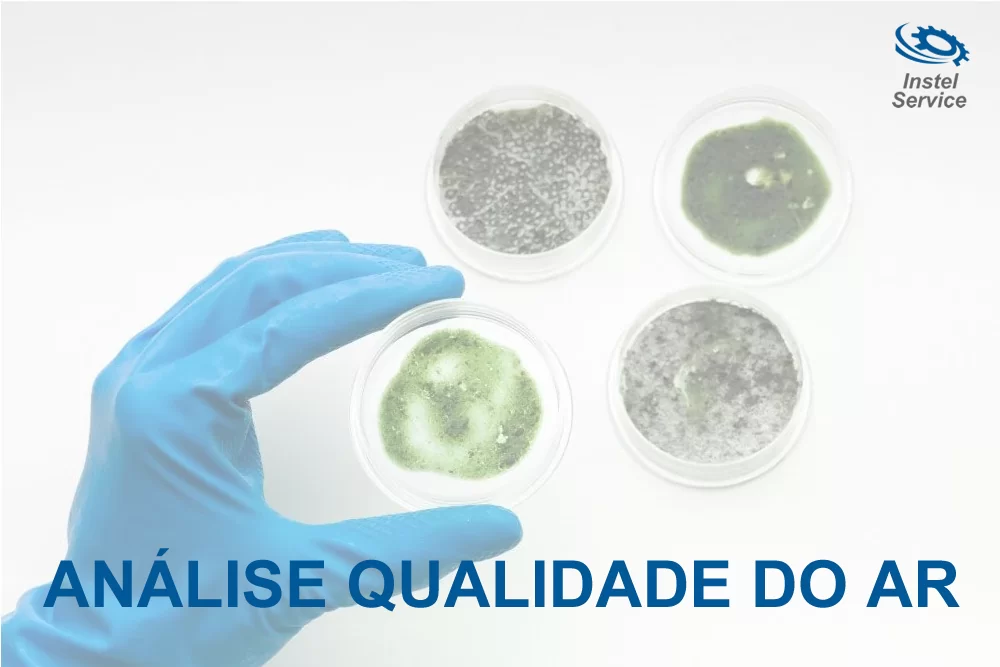

Dono ou Gestor de Transportadoras: Entenda a Importância do PMOC e Evite Multas da Anvisa!
Se você é o dono ou gestor de uma transportadora, é fundamental compreender a relevância do PMOC (Plano de Manutenção, Operação e Controle) para o seu negócio. A Anvisa realiza fiscalizações frequentes e está de olho na qualidade do ar em ambientes fechados, incluindo os veículos de transporte.
O PMOC é um documento essencial que assegura a adequada manutenção dos sistemas de climatização, visando a qualidade do ar e a saúde dos colaboradores. Ao implementá-lo corretamente, você estará evitando multas e problemas decorrentes da não conformidade com as regulamentações da Anvisa.
Nossa equipe especializada em PMOC pode auxiliá-lo em todo o processo. Realizamos uma análise minuciosa do ambiente de suas instalações e veículos, garantindo que todas as exigências da Anvisa sejam atendidas. Além disso, elaboramos um plano de manutenção personalizado, com base nas necessidades específicas da sua transportadora.
Ao adotar o PMOC, você estará protegendo seus colaboradores e passageiros, oferecendo um ambiente mais saudável e seguro durante o transporte. Também estará demonstrando comprometimento com a qualidade do ar e o bem-estar de todos.
Não arrisque receber multas e notificações da Anvisa. Entre em contato conosco e saiba mais sobre como podemos ajudá-lo a implementar o PMOC em sua transportadora, assegurando a conformidade com as normas e garantindo o melhor ambiente possível para seus colaboradores e passageiros.
Qualidade do Ar: A Preocupação Central da Anvisa
O Plano de Manutenção, Operação e Controle (PMOC) é um documento fundamental para garantir a qualidade do ar em ambientes climatizados. Um dos subdocumentos essenciais no PMOC é a análise da qualidade do ar, que desempenha um papel crucial na manutenção de ambientes saudáveis e seguros para as pessoas que os frequentam.
A qualidade do ar é um aspecto crítico para a saúde e o bem-estar das pessoas, especialmente em espaços fechados onde passamos a maior parte do nosso tempo, como escritórios, escolas, hospitais, laboratórios, shoppings, supermercados e até mesmo em nossas casas. Uma má qualidade do ar pode levar a problemas respiratórios, alergias, irritações oculares, entre outros efeitos negativos à saúde.
A análise da qualidade do ar consiste em avaliar diversos parâmetros, como a concentração de poluentes, partículas suspensas, níveis de dióxido de carbono (CO2), umidade relativa, temperatura e presença de microrganismos, como fungos e bactérias. Essa avaliação é realizada por profissionais especializados, por meio de amostragens e medições em diferentes pontos do ambiente.
A partir dos resultados da análise, é possível identificar possíveis problemas relacionados à qualidade do ar, como a presença de substâncias nocivas ou a falta de renovação adequada do ar. Com base nessas informações, são definidas as ações de manutenção e limpeza necessárias para garantir um ambiente saudável e seguro.
As manutenções são realizadas regularmente para garantir que os sistemas de climatização estejam funcionando de forma adequada, evitando o acúmulo de poeira, sujeira e microrganismos nos equipamentos. Além disso, é essencial que a renovação do ar seja adequada, garantindo a circulação de ar fresco e a eliminação de poluentes.
Com o PMOC em conformidade e a análise da qualidade do ar sendo realizada de forma regular, você estará garantindo a saúde e o conforto de todos que frequentam o ambiente. Além disso, estará atendendo às exigências da legislação vigente e evitando possíveis autuações e multas por parte da Anvisa.
Portanto, investir na análise da qualidade do ar e na implementação correta do PMOC é uma medida preventiva e responsável, que traz benefícios tanto para a saúde das pessoas quanto para o funcionamento adequado dos sistemas de climatização em seu estabelecimento. Não deixe de se preocupar com a qualidade do ar, e conte com profissionais especializados para auxiliá-lo nesse processo. Sua empresa e seus clientes agradecem!
Entre em contato Agora!
Entre em contato com a Instel Service sua melhor opção em PMOC para transportadoras e solicite um orçamento. Tel: (11)2987-5942, WhatsApp:(11)2987-5942, Email:comercial@instelservice.com.br.



